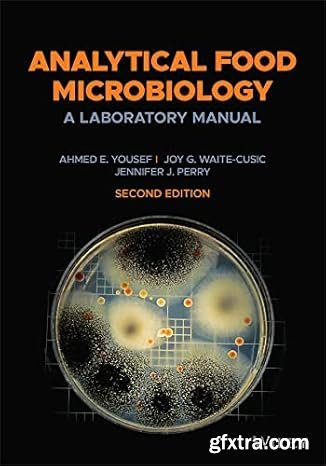
Analytical Food Microbiology: A Laboratory Manual, 2nd Edition

English | 130 pages | ISBN 10: 0 7641 4535 5 | ISBN 13: 978 0 7641 4535 3 | 2011 | PDF | 94.2 Mb
A QUARTO BOOK First edition for North America published in 2011 by Barron’s Educational Series, Inc. Copyright © 2011 Quarto Inc. All rights reserved. No part of this book may be reproduced or distributed in any form or by any means without the written permission of the copyright owner.

Agisoft Metashape (formerly PhotoScan) is a stand-alone software product that performs photogrammetric processing of digital images and generates 3D spatial data to be used in GIS applications, cultural heritage documentation, and visual effects production as well as for indirect measurements of objects of various scales.

English | 128 pages | ISBN-10 : 0804856397 | ISBN-13 : 978-0804856393 | October 17, 2023 | PDF | 60.4 Mb
In this lushly illustrated book, master painter and art teacher Hidenari Kobayashi provides step-by-step instructions to show you how to create attractive drawings and paintings in the popular French botanical style. He details all the tools and materials needed, describes the techniques you'll use, and walks you through the creative process of drawing and painting 18 different botanical subjects.

Asymmetric Synthesis of Natural Products 3e
by Ari M P Koskinen
English | 2022 | ISBN: 1119707021 | 387 pages | True PDF | 22.91 MB

English | 112 pages | ISBN-10 : 4805317485 | ISBN-13 : 978-4805317488 | October 31, 2023 | PDF | 22.8 Mb
A Beginner's Guide to Watercolor Painting is the perfect book for anyone who wants to experience the spontaneity of watercolor sketching with a water brush pen—a rewarding hobby that enables you to paint anytime, anywhere with very simple materials. The beginner-friendly lessons in this book contain all the information you need—detailed tips and instructions along with step-by-step photos to walk you through the process of painting everything from still life to portraits and landscapes.

Starry Night Pro Plus 8.1.1.2091 | 2.36 GB
Starry Night 8 - Professional Astronomy Telescope Control Software for PC. Starry Night Pro Plus 8 is our fully featured flagship program, tailored for the astronomer who wants the very best in-class astronomy software and telescope control experience.

English | August 29, 2024 | ASIN: B0DFQF9BR8 | 288 pages | PDF | 79 Mb

English | 184 pages | ISBN-10 : 4805316306 | ISBN-13 : 978-4805316306 | October 12, 2021 | PDF | 18.6 Mb
In this book, Japanese master artist Shozo Koike reveals the simple secrets of Sumi-e, offering step-by-step instructions with clear photographs and online video tutorials showing you how to paint 19 traditional subjects

ChrisPC VideoTube Downloader is a powerful software with a friendly user interface that allows you to download videos and playlists from YouTube, videos from Dailymotion, BBC iPlayer, ITV Player, ABC, FOX, CBS.com, Vimeo, Prosieben, Metacafe, Blip.tv, CBC.ca many more video websites. Once the videos are downloaded, you can convert them to formats compatible with iPad, iPhone, iPod, MPEG-4 H.264, MP3, AC3.

English | 128 pages | ISBN-10 : 0804856230 | ISBN-13 : 978-0804856232 | PDF | 101 Mb
In this book, sketching and painting expert Masao Yamada provides dozens of examples showing you how to establish accurate perspective guidelines and proportions for your initial pencil sketches, setting your drawings up to succeed right from the start. If a sketch's perspective and proportions are correct, your finished work will look crisp and beautiful. If not, you'll have a frustrating time trying to correct the problems at a later stage—and the finished work will never look quite right. A Beginner's Guide to Sketching Buildings & Landscapes is here to help you avoid those frustrations and set up your composition for a finished piece that will make you proud.

English | 128 pages | ISBN-10 : 0804856249| ISBN-13 : 978-0804856249 | PDF | 28.2 Mb
A Beginner's Guide to Colored Pencil Drawing provides instructions for creating brilliantly realistic drawings featuring rich shadows, bright highlights, smooth gradients, and glowing colors. Learn at your own pace over the course of 14 easy-to-follow lessons!

XLN Audio RC-20 Retro Color 1.3.4 macOS | U2B | 133.81 MB
XLN Audio's RC-20 Retro Color is a creative effect plugin that adds life and texture to any recording. It easily recreates the warm, cozy feeling of vintage recording equipment, but also works perfectly in any modern production setting.

XLN Audio DS-10 Drum Shaper 1.2.5 macOS | U2B | 76.77 MB
DS-10 is a transient shaper designed specifically for use with drums. The clutter-free interface lets you dial in just the right amount of punch in your drum mixes while three amazing algorithms provide great sounding results.

XLN Audio Life 1.1.3 macOS | U2B | 396.58 MB
Life by XLN Audio lets you generate infinite beats with the unique sounds from your life's favorite moments. Capture anything, anywhere, anytime with Life's accompanying mobile Field Recorder and DAW Recorder apps.

XLN Audio XO 1.7.1 macOS | U2B | 993.49 MB
XO is the new generation drum sequencer. XO identifies and collects single samples stored anywhere on your computer or hard drives and sorts them by similarity. This gives your selected samples a new creative context that makes experimentation easier. XO can be used to create beats and rhythms if you load drum sounds into it.

English | 144 pages | ISBN-10 : 476831144X | ISBN-13 : 978-4768311448 | PDF | 15.2 Mb
This book explains how to draw and paint skin in cute girl illustrations, but we have emphasized the tips for expressing "realistic skin" rather than simply drawing and painting. In this book, "realistic skin in cute girl illustrations" means, for example, that the face is deformed but the breasts and stomach are realistically expressed, or that specific parts of the body that should stand out are drawn in.

A common problem we often face with, when uninstalling unnecessary software, is various traces left in the system: unneeded files or folders on a disk, registry entries and so on. This can happen even if an application was removed correctly with its own uninstaller - a special program provided by a vendor to uninstall the application. The Soft Organizer program is intended to solve this problem: It allows you to COMPLETELY uninstall unnecessary applications from your system.

English | December 9, 2024 | ASIN: B0DQ1ZDL2G | 184 pages | PDF | 12 Mb

Principles of Physical Optics 2e
by Charles A Bennett
English | 2022 | ISBN: 1119801796 | 595 pages | True PDF | 45.03 MB

High Voltage and Electrical Insulation Engineering, Second Edition
by Ravindra Arora
English | 2022 | ISBN: 1119568870 | 505 pages | True PDF | 17.75 MB

Power System Relaying
by H. Horowitz, Arun G. Phadke and Charles F. Henville
English | 2022 | ISBN: 1119838436 | 525 pages | True PDF | 41.93 MB

Electrochemical Methods
by Allen J Bard
English | 2022 | ISBN: 1119334063 | 1107 pages | True PDF | 60.47 MB

How the Immune System Works
by Lauren Sompayrac.
English | 2022 | ISBN: 1119890683 | 176 pages | True PDF | 13.3 MB
Analytical Food Microbiology: A Laboratory Manual
by Ahmed E. Yousef
English | 2022 | ISBN: 0470425113 | 399 pages | True PDF | 26.83 MB
Top Rated News
- CreativeLive Tutorial Collections
- Fasttracktutorials Course
- Chaos Cosmos Library
- MRMockup - Mockup Bundle
- Finding North Photography
- Sean Archer
- John Gress Photography
- Motion Science
- AwTeaches
- Learn Squared
- PhotoWhoa
- Houdini-Course
- Photigy
- August Dering Photography
- StudioGuti
- Creatoom
- Creature Art Teacher
- Creator Foundry
- Patreon Collections
- Udemy - Turkce
- BigFilms
- Jerry Ghionis
- ACIDBITE
- BigMediumSmall
- Globe Plants
- Unleashed Education
- The School of Photography
- Visual Education
- LeartesStudios - Cosmos
- Fxphd
- All Veer Fancy Collection!
- All OJO Images
- All ZZVe Vectors
- CGTrader 1 CGTrader 2






















